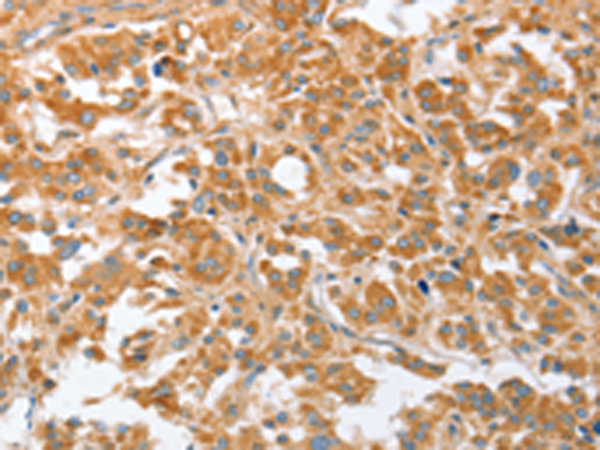
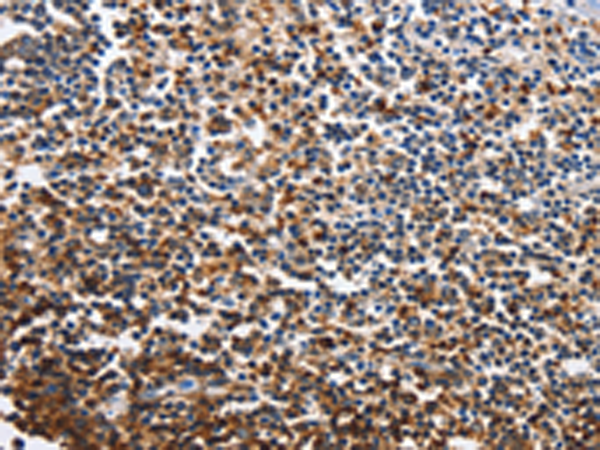
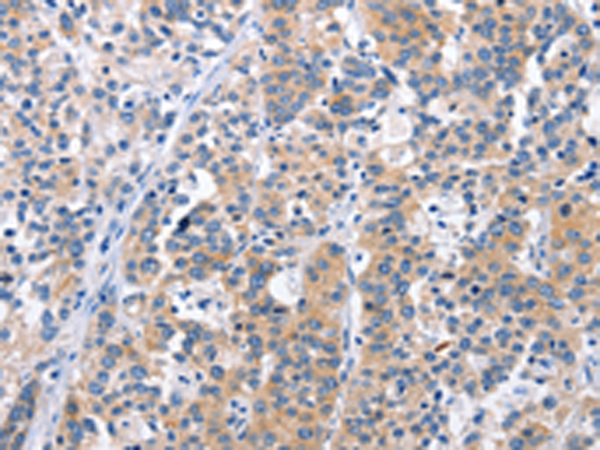

-
分类: 科研抗体货号: P08129别名: T14; S152; Tp55; TNFRSF7; S152. LPFS2应用: WB,IHC反应种属: Human
-
分类: 科研抗体货号: P08123别名: NB1; PRV1; HNA2A; PRV-1; HNA-2a; NB1 GP应用: IHC反应种属: Human
-
分类: 科研抗体货号: P08126别名: SIGLEC2; SIGLEC-2应用: IHC反应种属: Human
-
分类: 科研抗体货号: P08120别名: NK1; BY55; NK28应用: WB,IHC反应种属: Human
-
分类: 科研抗体货号: P08143别名: Yo; CDR62应用: IHC反应种属: Human, Mouse
-
分类: 科研抗体货号: P08119别名: p58; NKAT; GL183; NKAT2; CD158b; KIR2DL; NKAT2A; NKAT2B; CD158B2; KIR-K7b; KIR-K7c; KIR2DS5; KIRCL23; KIR-023GB应用: IHC反应种属: Human
-
分类: 科研抗体货号: P08142别名:应用: IHC反应种属: Human, Mouse, Rat
-
分类: 科研抗体货号: P08150别名: LRRIQ2; 2810403B08Rik应用: WB,IHC反应种属: Human
-
分类: 科研抗体货号: P08139别名: AGO; CDC4; FBW6; FBW7; hAgo; FBX30; FBXW6; SEL10; hCdc4; FBXO30; SEL-10应用: IHC反应种属: Human, Mouse
-
分类: 科研抗体货号: P08149别名: CT111; URCC6; C10orf3应用: WB反应种属: Human, Mouse, Rat

鄂公网安备42018502007531号
鄂公网安备42018502007531号

